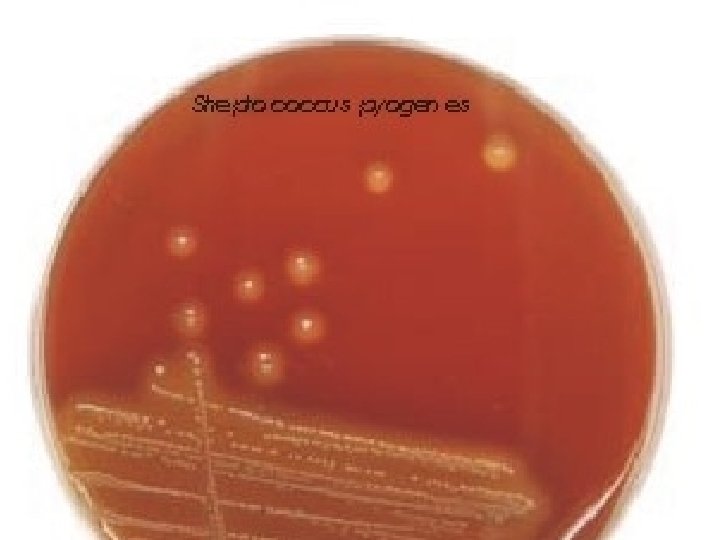

Streptococci Lecture 5 Medical Microbiology SBM 2044 Streptococcus

Streptococci Lecture 5 Medical Microbiology SBM 2044

Streptococcus Ø Ø Gram-positive Grow in chains Non-motile Facultative anaerobes Ø 3 types of streptococci classification: • Early studies distinguished 3 broad groups on blood agar • a-haemolytic • non-haemolytic • b-haemolytic • Group-specific antigens (Lancefield classification) – by serological reactivity of extracted cell wall antigens (A U) • Species – biochemical tests

Streptococcus pyogenes Ø Natural habitat: Humans Ø Strains distinguished by M serotyping • Devised by Lancefield in 1920 s, using panels of absorbed sera to hot-HCl extracted antigen, she called “M antigen” • M-type specific antigen was sensitive to proteases M proteins • > 100 distinct M types of GAS distinguished since then - called M 1, M 2, M 3, M 4, ……. . etc. Ø Highly versatile pathogen • Suppurative infections • Toxinogenic diseases • Immunologically-mediated diseases

Ø GAS diseases – changing patterns • Changes in virulence of prevailing GAS strains ? • Changes in social conditions – less crowding? Ø Reemergence of severe invasive infections • Sporadic cases since mid-1980 s – new virulent strains? • Streptococcal toxic shock o Some cases associated with obviously severe tissue infections o Many others – shock following mild or unapparent infections • Sporadic – implies predisposing factors

Group A Streptococci Principle sites of infection: Pharynx Skin Deep-seated tissues Local spread (e. g. ) Invasive infections Pharyngitis, tonsillitis, otitis media, sinusitis. Other tissues pyroderma, erysipelas Occasionally Extensive necrosis (necrotizing fasciitis) Bacteraemia or septicaemia Streptococcal Toxic Shock • Puerperal fever (childbirth fever) in women – major killer in past

Streptococcus pyogenes Tonsillitis Follicular tonsillitis

Streptococcus pyogenes Impetigo Cellulitis Erysipleas

Streptococcus pyogenes Necrotizing fasciitis (< 24 hours post surgery)

Streptococcus pyogenes Scarlet fever

Group A Streptococci • Encounter – Carriers appear asymptomatic – Person-to-person spread is mediated by respiratory droplets or by direct contact to skin • Entry – For pyodermal infections, streptococci need to gain entry into deeper layers of skin – In pharyngeal infections, to prevent from being swept away, GAS must adhere to lipoteichoic acid (LTA), protein F and/or M protein

M protein • Important for cell adherence to keratinocytes • Prevent opsonization by complement – bind to fibrinogen and interferes with the alternative pathway – bind with host complement control proteins and inhibit opsonins formation • Hypervariable regions of M protein are antigenic, but there are > 100 M protein serotypes

EM showing the M Proteins (hair-like surface structures) of S. pyogenes

Group A Streptococci • Spread and multiplication – Most GAS remain localised to the site of initial infection – In pharynx and tonsils, may result in erythema and exudate associated with strep throat – Peritonsillar abscess (quinsy) or spread to adjacent structures (mastoid and middle ear) – Impetigo in skin – Erysipelas and cellulitis in deeper layers of skin – GAS may spread laterally in deep tissues, by secreting enzymes • necrotizing fasciitis and myositis

GAS virulence factors – Excreted products Ø Cytolytic toxins • Streptolyxin O (SLO) Produced by all strains • Streptolysin S (SLS) • Both lyse wide range of cells, including PMNs suppuration and/or necrosis • Various subtle effects at sub-lytic concentrations • SLO – ‘sensitive’ to O 2 “Thiol-activated” toxin • SLS – stable in O 2 b-haemolysis

SLO- and SLS-defective mutants Ø murine s. c. model - weight loss at 24 h post infection Sterile ~3 x 109 cfu + 0. 5 ~3 x 108 cfu ~3 x 107 cfu ~3 x 106 cfu ~3 x 105 cfu Weight gain (grams) 0. 0 - 0. 5 - 1. 0 - 1. 5 - 2. 0 - 2. 5 PBS WT sloΔ 1 sag. BΔ 1 sloΔ 1 sag. BΔ 1

Hyaluronic acid capsule • Antiphagocytic structure on bacterial surface • Hyaluronic acid is abundant in human connective tissue - hence GAS can camouflaged themselves • But capsule may interfere with the adherence of GAS to epithelial cells – so GAS shed the capsule during the early stages of infection using hyaluronidase

Secreted protein Function Proteases Hyaluronidase spreading factor Streptolysins S and O form pores in the host membranes Deoxyribonucleases (DNase) Streptokinase – bind to human protein plasminogen, and convert this to plasmin degrades fibrin

Damage • GAS can evoke an intense inflammatory responses in tissues • Streptococcal pyrogenic exotoxins (SPE) – SPE A, B and C cause rash, a characteristic of scarlet fever – SPE A and C are bacterial superantigens that activate a large subset of T cells • Immunologically mediated disease (nonsuppurative sequelae) – acute rheumatic fever (ARF) – acute post-streptococcal glomerulonephritis

Toxic Shock Ø In past – probably linked to scarlet fever Ø Since mid-1980 s – associated with ‘new’ highly virulent strains - rapidly fulminating • some cases in previously healthy young adults, no obvious predisposing factors Ø Associated with production of superantigenic toxins, but other factors also involved

Acute rheumatic fever (ARF) Ø autoimmune disease - triggered only by GAS pharyngitis Ø associated with strong immune response to GAS. • antibodies and/or T cells X-react with host antigens? (later) Ø Symptoms arise > 10 days + after GAS infection • responsible GAS strain already ‘cleared’ Ø Symptoms may include: • inflammation multiple sites, starting with major joints (arthritis) • neurological disorders (Sydenhams chorea) • rheumatic heart disease (RHD) (ca 50% cases) - damage to heart valves, permanent scaring in survivors

Acute rheumatic fever (ARF) Ø Initial attack rates low (3% in untreated pharyngitis) Ø High recurrence (up to 50%) - increasing in severity Widespread prescription of penicillin for ‘sore throats’ Remarkably, GAS have not (yet ? ) developed resistance to penicillins

GAS infections - complications Post-streptococcal acute glomerulonephritis (PSGN): Ø Common, but rarely life-treating - some GAS infections of either pharynx or skin. Ø Symptoms arise some 10 days after infection • reflect kidney dysfunction, probably involving inflammation of glomeruli Ø Pathogenesis: • Most probably entrapment of GAS antigen-host antibody complexes at basement membranes of glomeruli • might also involve an ‘autoimmune’ response

Normal glomerulus Glomerulonephritis Mesangial cell intrusion Mesangial cell Endothelial cell, has 100 nm pores PMN Basement membrane Small complexes diffuse thro’ basement membrane into urine, but the occasional larger complex can’t & is normally removed by mesangial cell Inflammation Too much large immune complex entrapment ? Example: Sequel of some S. pyogenes infections

Treatment and Prevention • Penicillin – 10 day oral therapy • Erythromycin or other macrolide antibiotics for individuals allergic to penicillin

Group B streptococci • Streptococcus agalactiae are aerobic G+ diplococci that are β-haemolytic on blood agar plates – found in lower GIT and female genital tracts – GBS is a leading cause of neonatal sepsis and meningitis – prevent opsonization and phagocytosis with a polysaccharide capsule

Enterococci • Enterococcus faecalis cause UTI, wound infections, endocarditis, intraabdominal abscesses and bacteremia. – – – Normal flora of GIT and GUT resistant to bile and high salt concentrations nosocomial infections resistance to many antibiotics, often bacteriostatic bacterial killing must use a combination treatment of a β-lactam and an aminoglycoside
- Slides: 27